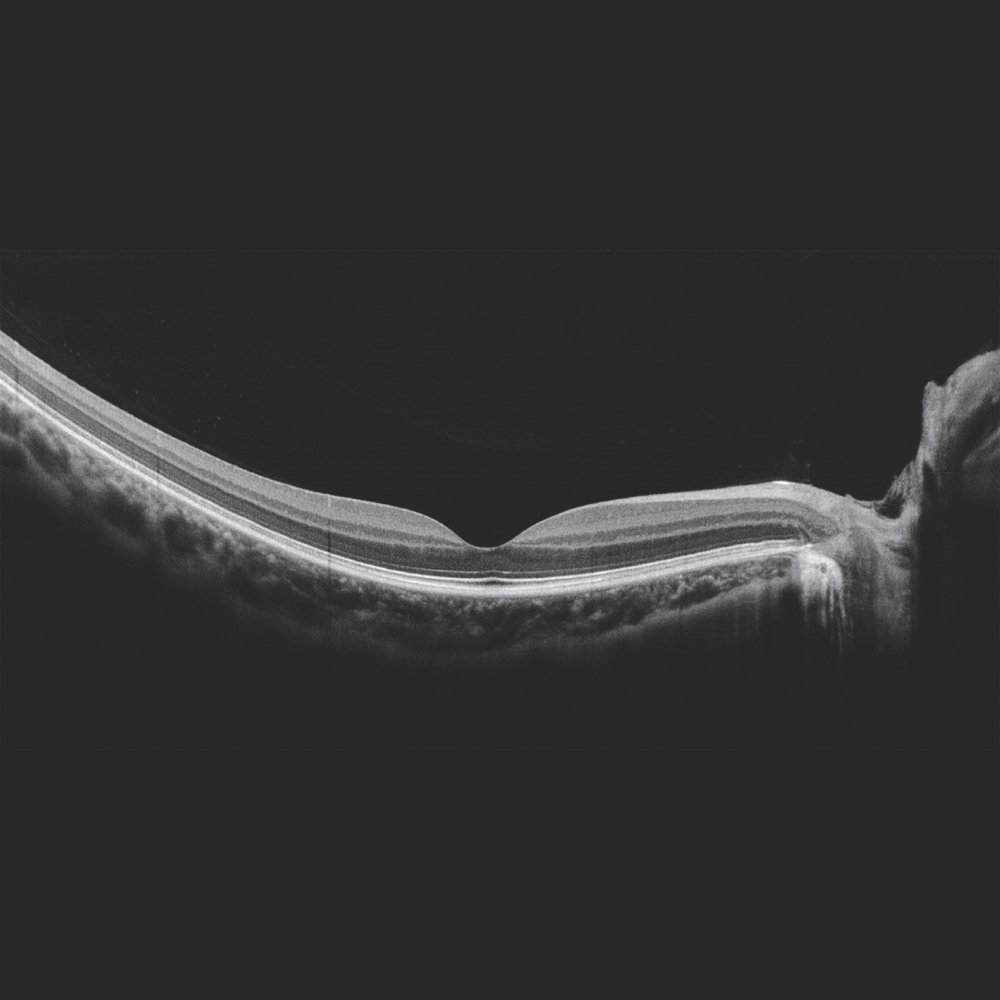

The Mocean 3000 is an advanced Spectral Domain OCT system that incorporates Artificial Intelligence (AI) technology to provide high-resolution diagnostic imaging.
By combining advanced SD-OCT technology with precision Scanning Laser Ophthalmoscopy (SLO), the Mocean 3000 ensures exceptional clarity, high-speed acquisition, and superior diagnostic reliability for the retina, glaucoma, and anterior segment.
Overview
-
Spectral Domain OCT technology with 50,000 A-scans/sec for efficient workflow and reliable data acquisition
-
AI-enhanced automated analysis for precise layer segmentation and detection of retinal pathologies
-
Widefield 10×10 mm 3D PanoScan enabling comprehensive retinal assessment in a single high-resolution scan
-
Real-time SLO fundus imaging (45°) with eye tracking for precise alignment and reduced motion artifacts
-
Comprehensive 16 mm angle-to-angle scan for complete anterior segment and corneal evaluation
-
Automated analysis tools including retinal, glaucoma (RNFL & GCC), and choroidal thickness assessment
Advanced Imaging Capabilities
The Mocean 3000 excels through the simultaneous acquisition of SD-OCT and SLO imaging. This integrated approach, powered by AI-driven software, allows clinicians to accurately localize lesions on the fundus, ensuring unmatched clinical precision and reproducibility.
With a digital axial resolution of 2.7 μm, the system reveals the finest structural details, empowering practitioners to detect subtle pathologies.
Scalable Performance: Upgrade to OCT Angiography (OCTA)
The Mocean 3000 offers the optional upgrade to the VASCAN™ OCTA module, enabling non-invasive, dye-free visualization of the retinal microvasculature. It provides high-definition vascular imaging, quantitative AI analysis (vessel density, FAZ), and enhanced management of vascular conditions.